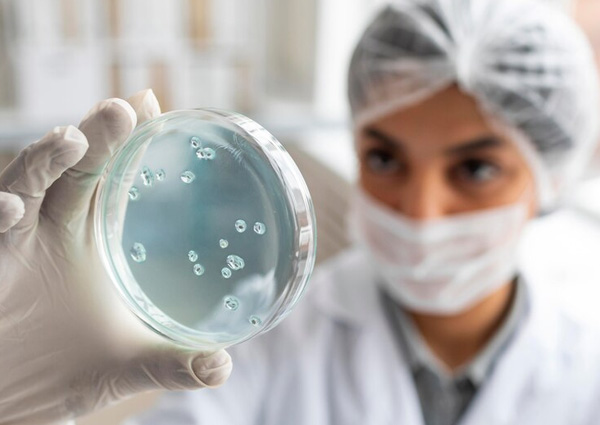

Week 1: Foundations
Biochemistry, molecular biology, and general principles — the essential building blocks.
With over two decades of USMLE prep experience, Dr. Iliou has mentored hundreds of successful Step 1 candidates across the globe.
Real-time teaching, Q&A sessions, and active case-based learning delivered via Zoom.
Designed to target exam-relevant material with a balance of theory and clinical application.
Attend from anywhere and stay on track with a weekly schedule, session recordings, and dedicated support.
Dr. Claude-Bernard Iliou received a Bachelor of Science degree from the Massachusetts Institute of Technology in 1983. Following this, he spent 2 years at the Massachusetts General Hospital characterizing and purifying the alpha-1 adrenergic receptor in the Department of Molecular and Cellular Research with Edgar Haber, M.D. Dr. Iliou attended the Howard University College of Medicine from 1985 to 1989 where he graduated with honors in surgery. He did an internal medicine residency followed by an anesthesiology residency at the Einstein College of Medicine and Montefiore Hospital Center, respectively. He worked for a few years in clinical practice before opening his own practice in Pain management in 1997. He received training for the insertion of programmable pumps and stimulators in 1999. He became the Medical Director of several health centers and founded a Chronic Pain support group in Southwest Florida. During that period, he also participated in a number of large clinical trials for Verapamil and PEG-interferon. His inexhaustible passion for teaching was evident as a medical speaker for 7 different pharmaceutical companies between 1997 and 2004.
Over the course of 7 intensive weeks, you’ll cover all core Step 1 topics and build a strong exam foundation:

Week 1: Foundations
Biochemistry, molecular biology, and general principles — the essential building blocks.

Week 2: Challenging material
Physiology, Pharmacology and core systems: CVS< Respiratory and Renal
Week 3: Microbiology & Immunology
Pathogens, immune responses, hypersensitivities, and vaccines.

Week 4: Pathology Bootcamp
Comprehensive systems-based pathology review with clinical correlations.

Week 5: Systems Reviews
GI, Endocrine, Genital Tract and Heme/Onc

Week 6: Behavioral Sciences and Biostatistics
Case studies, high-yield pearls, and board-style MCQs.

Week 7: Practice Exams & Review Marathon
Two full-length NBME-style mock exams with guided feedback and strategy sessions.
Registration Deadline: June 26th
All sessions are recorded and made available to enrolled students for on-demand viewing.
Yes. Two full-length mock exams are included in Week 7 with instructor-guided debriefs.
Absolutely. Test-taking techniques and pattern recognition are a key component of the program.
Certificate of completion will be issued to students who have reached a minimum 80% attendance and have successfully completed at least 90% of the assigned material and both mock exams.
Our team is here to help.